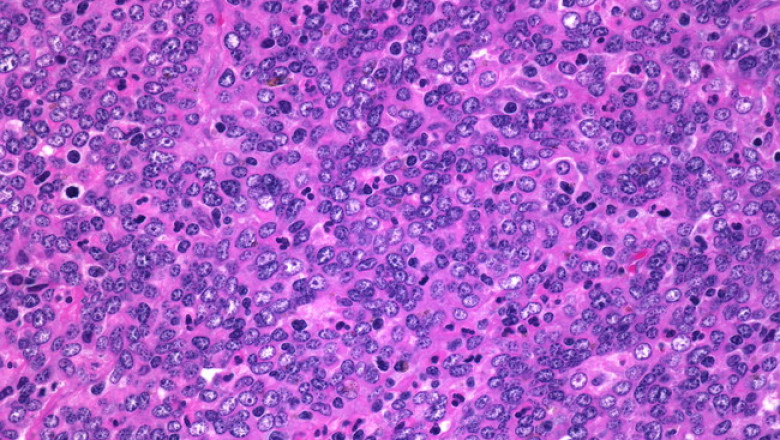

views
The International Agency for Research on Cancer (IARC) is part of the World Health Organization (WHO). Its main goal is to determine the cause of cancer. IARC concluded that formaldehyde is "carcinogenic to humans" and needs to be removed because of its higher risk of nasopharyngeal cancer and leukemia.
* Contact EnviroSafe for disinfection and sterilization services or formaldehyde removal (除甲醛) services, and will provide professional and high-quality environmental safety services.
The Environmental Protection Agency (EPA) maintains the Integrated Risk Information System (IRIS), an electronic database containing information on the human health effects of exposure to various substances in the environment. The U.S. Environmental Protection Agency has classified formaldehyde as a "probable human causative agent."
Researchers at the National Cancer Institute have concluded that exposure to formaldehyde may cause human leukemia, particularly myeloid leukemia, based on data from human studies and laboratory studies.
(For more information on the classification systems used by some of these agencies, see Known and Probable Human Carcinogens.)
Symptoms of Formaldehyde Exposure
high level exposure
The main toxic effects from acute formaldehyde exposure by inhalation are eye, nose and throat irritation and effects on the nasal cavity. Other effects of human exposure to high levels of formaldehyde include coughing, wheezing, chest pain and bronchitis.
low level exposure
Formaldehyde levels commonly found in consumer products can irritate the eyes, nose, throat and lungs. These sensory stimuli are often described as itching, pain, or burning. Formaldehyde may have small, reversible effects on lung function at concentrations higher than those associated with sensory stimuli.
Some people are more sensitive to the effects of formaldehyde than others. For the general population, skin contact with a solution of formaldehyde at a concentration of approximately 1% to 2% may cause skin irritation. However, allergic people develop contact dermatitis after exposure to concentrations as low as 0.003% formaldehyde.
There is no evidence that formaldehyde causes birth defects in humans, or that formaldehyde absorbed by the mother can be passed on to the baby through the placenta or breast milk.